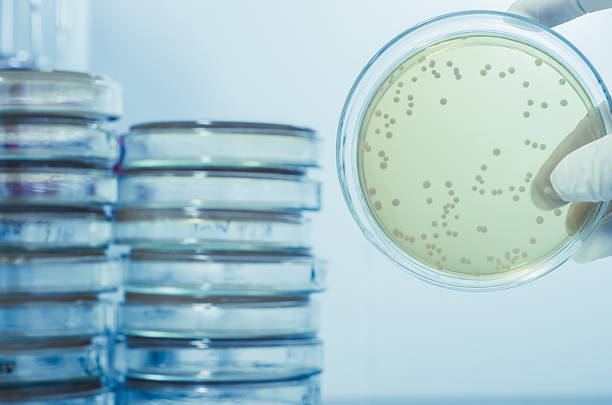

Monstername en advies
-
Bij H2O Enterprise bieden we een breed scala aan meetprogramma’s aan, waaronder verplichte monsternames. Deze programma’s zijn cruciaal voor de veiligheid en hygiëne van installaties. Of het nu gaat om periodieke Legionella-tests, zwembadwateranalyses, of bacteriologische onderzoeken, wij zorgen voor nauwkeurige en betrouwbare resultaten.
-
In samenwerking met onze partners kunnen wij u ook meetprogramma's op maat aanbieden welke aansluiten op uw specifieke situatie en behoeften. Daarnaast bieden wij u volledige ondersteuning en begeleiding gedurende het gehele proces. Van de eerste analyse tot de implementatie en opvolging, wij staan aan uw zijde om ervoor te zorgen dat u de beste resultaten behaalt en eventuele risico's tot een minimum beperkt.
-

Periodieke Legionella Monsternames
Regelmatige controles om de veiligheid van uw drinkwater te waarborgen en aan de wettelijke eisen te voldoen.
-

Zwembadwater Analyse
Analyse van zwemwater om de gezondheid van gebruikers te beschermen en te voldoen aan de richtlijnen voor zwembadbeheer.
-

Bacteriologische Onderzoeken
Grondige bacteriologische testen voor verschillende soorten water om een veilige en schone omgeving te garanderen.
-
Samenwerking met lokale laboratoria
Wij werken nauw samen met lokale laboratoria die volledig geaccrediteerd zijn. Dit betekent dat al onze analyses onder strikte kwaliteitsnormen worden uitgevoerd, wat snelle en betrouwbare resultaten garandeert. U kunt erop vertrouwen dat uw waterkwaliteit in goede handen is.
-
Advies op maat
Onze adviseurs bij H2O Enterprise denken met u mee. We bieden advies op maat bij de analyseresultaten en werken samen naar een oplossing bij overschrijdingen. Tevens ondersteunen wij u in het uitzetten van vervolgstappen zoals spoelwerkzaamheden, brononderzoeken of reinigingen.
-
Interesse in onze meetprogramma’s?
Neem contact met ons op voor meer informatie of om direct een afspraak te maken. Wij helpen u graag verder met deskundig advies en betrouwbare wateranalyses.
Contactformulier
-
H2O Enterprise
Steenbakkerij 11
2913 LJ Nieuwerkerk a.d. IJssel
-
Contact